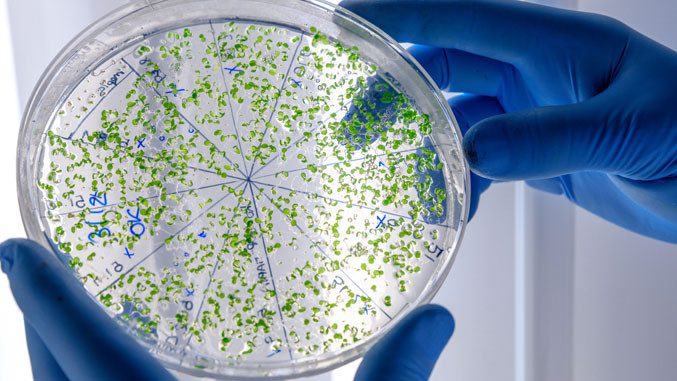

Nakon više od dve godine ogromnih napora vlada širom sveta, kovid više nije najveći globalni infektivni ubica. Sada je ponovo na neslavnom tronu tuberkuloza, upozoravaju stručnjaci.
Predsednik neprofitne organizacije „TB alijansa” Mel Spigelman pohvalio je velike napore i napredak u borbi protiv pandemije kovida, uvođenje brojnih mera i razvoj efikasnih vakcina, testiranja i tretmana. Prema njegovim rečima, prenosi RTS, samo delić takvih napora se ulaže u borbu protiv tuberkuloze.
Tuberkuloza je pre pojave kovida, decenijama bila najveći infektivni ubica sa oko 1,5 žrtava godišnje širom sveta.
„Sa zaustavljanjem pandemije i postepenim opadanjem broja žrtava od kovida, tuberkuloza je preuzela svoju titulu”, naveo je Spigelman.
„TB alijansa” naglašava činjenicu da dnevno od tuberkuloze umire 4.109 ljudi širom sveta. U poređenju sa novijim brojkama, od kovida-19 prethodnog meseca u svetu je dnevno umiralo 1.449 ljudi, pokazuju podaci Univerziteta Džons Hopkins.